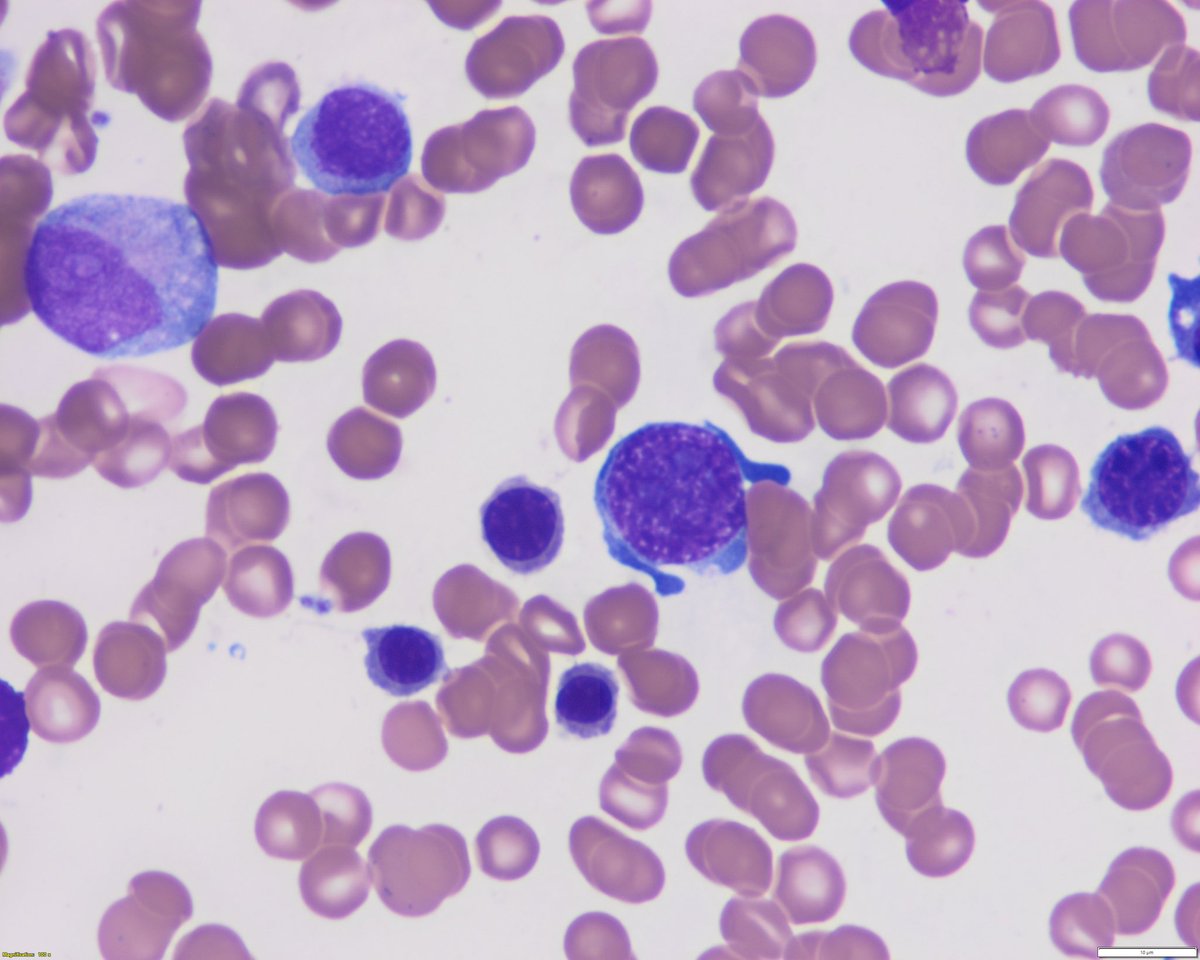
Sanam Loghavi, MD صنم لغوی 🔬🧬 tweet media
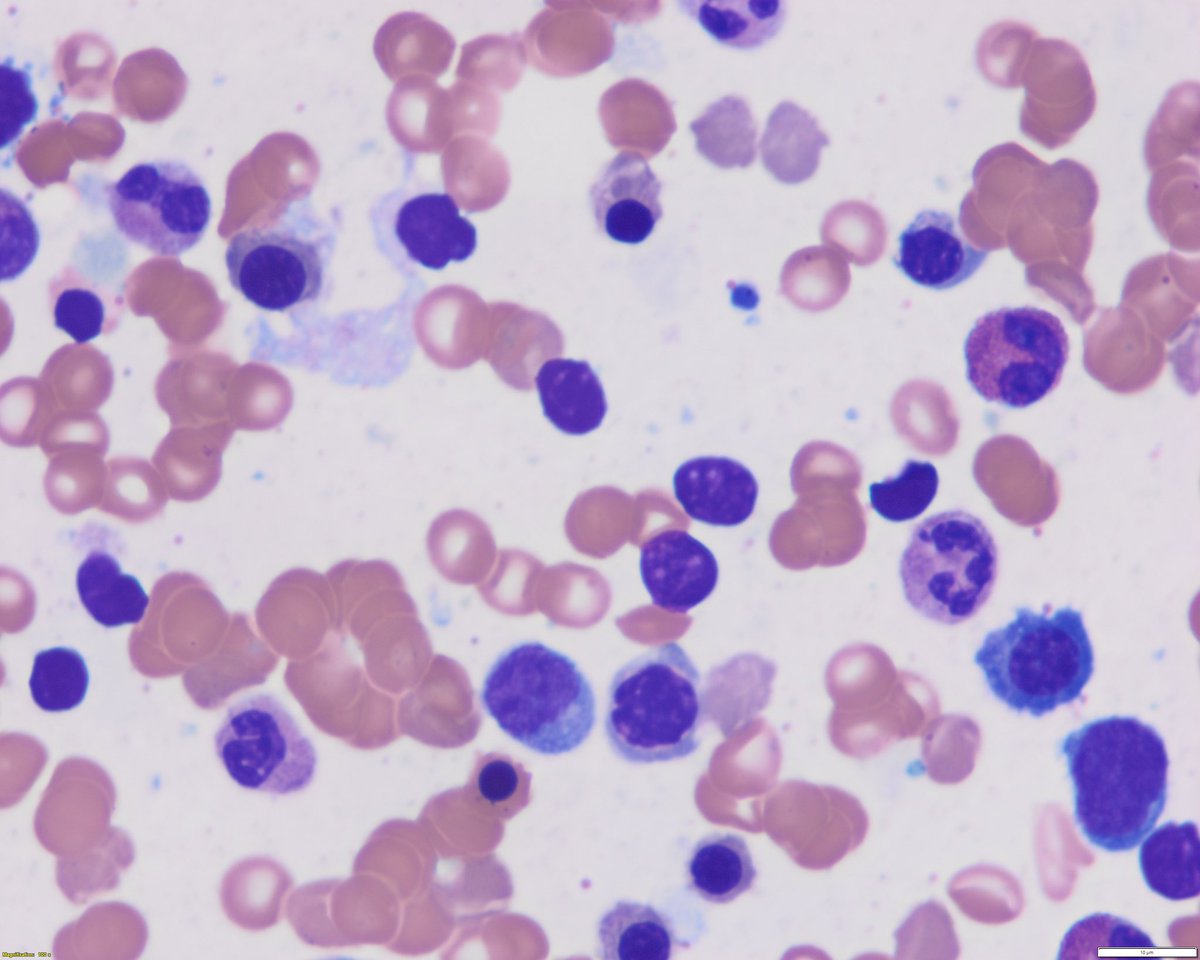
Sanam Loghavi, MD صنم لغوی 🔬🧬 tweet media

Tim Pardee/F3 Splash
544 posts

Tim Pardee/F3 Splash
@TimPardee1
World's most ok-est runner, Science nerd and anti-leukemia activist
Katılım Mart 2013
642 Takip Edilen151 Takipçiler

@BuffaloBills @MillerLite Western North Carolina says GO BILLS!!!
English

🚨 Wild Card Weekend Roll Call 🚨
Tell us where you're representing #BillsMafia from today!
@MillerLite | #MIAvsBUF

English

Hey all, So the Bills Mafia Area Code shout out is now up to 210 Area codes. Also, we're starting to go international - Scotland,Portugal, UK,Montreal,Nova Scotia. Keep em coming and I will add. Go Bills... #billsmafia
English
Tim Pardee/F3 Splash retweetledi

So you want to get in better shape? You want to be a better man? Don’t go alone. Join other men with the same mission. Find a workout near you and just show up. That’s it. No catch. f3nation.com/workouts/
English
Tim Pardee/F3 Splash retweetledi

@sanamloghavi Simple clinician reply is low grade MDS, no indication for treatment at the present time. Follow the patient q3-6 months for worsening cytopenias.
English

Hey fam, need a favor.
Unfortunately Greyson is stuck in the hospital and heartbroken he can’t be home for Santa.
We will be watching the game from the comforts of our room at UMass, but I’m trying my best to boost his spirits
Can he get some “GO BILLS” fam?
#BillsMafia

English

@beardedphotog24 That’s so weird! I want those things for Christmas 🎄! Hope it’s a great day and we both get our wishes for a Bills W! Go Bills!!!
English

All I want for my birthday is a Buffalo Bills win, and a third consecutive AFC East Division Title.
Game Day Coffee Selfie ☑️
This is 39.
Go Bills ! #BillsMafia

New York, USA 🇺🇸 English

@nihardesai7 Periphal blasts of a few % can be seen in leukamoid reactions and don’t necessarily mean a diseased marrow. However if you have neutropenia and circulating blasts that is never normal!
English

Hey #medicine residents !!
If you find >20% blasts on a peripheral smear, please, please refer to a hematologist as soon as possible 🙏🏻
#MedTwitter
English
Tim Pardee/F3 Splash retweetledi

𝐑𝐄𝐓𝐖𝐄𝐄𝐓 𝐓𝐎 𝐕𝐎𝐓𝐄‼️
#ProBowlVote | @JoshAllenQB
#ProBowlVote | @StefonDiggs
#ProBowlVote | @GabeDavis13_
#ProBowlVote | @Dawson_Knox
#ProBowlVote | @DDawkins66
#ProBowlVote | @MithenMor60

English

As you know, I love my @BuffaloBills and I’m watching another big game today. As we say: “Let’s Go Buffalo.” #GoBills!

English

@sanamloghavi Actually think they left 7q- out of the table by mistake as they mention bad prognosis associated with it in the text. Thanks for a great post!
English

Interestingly, ELN 2022 only considers monosomy 7 (not del7q) as adverse-risk.. bit.ly/3h2QGwQ
But this is debatable as they also recommend classifying del7q as myelodysplasia-related and many studies show del7q is ass/w poor prognosis 3/3 #hemepath


English